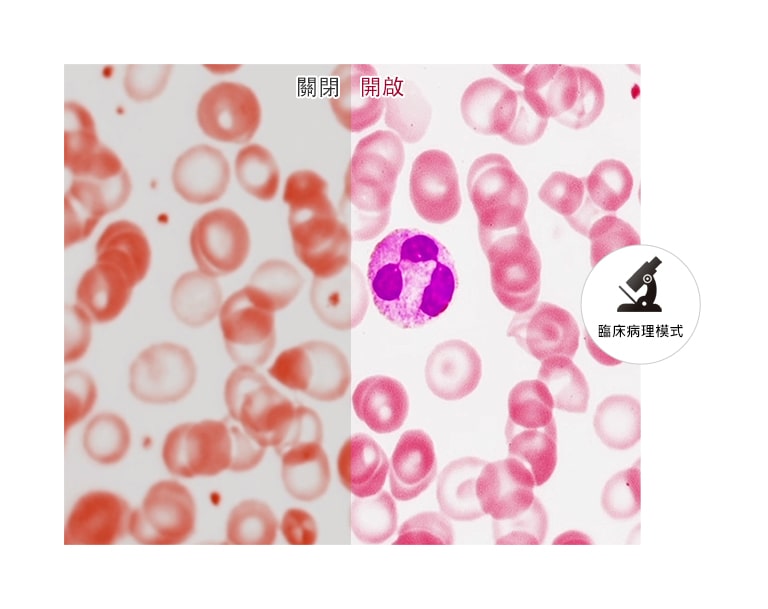

We use cookies, including cookies from third parties, to enhance your user experience and the effectiveness of our marketing activities. These cookies are performance, analytics and advertising cookies, please see our Privacy and Cookie policy for further information. If you agree to all of our cookies select “Accept all” or select “Cookie Settings” to see which cookies we use and choose which ones you would like to accept.
LG 8MP 診斷型醫療顯示器
為診斷檢查提供最佳畫質
提高效率和便利性
所有規格
電源
AC Input
100-240Vac, 50/60Hz
DC Output
19V, 3.42A
Power Consumption (DC Off)
Less than 0.3W
Power Consumption (Max.)
65W
Power Consumption (Sleep Mode)
Less than 1.2W
Type
External Power (Adapter)
配件
變壓器
Yes
校色報告 (紙本)
Yes
Display Port
Yes
HDMI
Yes
電源線
Yes
顯示功能
面板尺寸
31.5 Inch
解析度
3840 x 2160
面板比例
16:9
亮度 (Typ.)
450
亮度 (DICOM Cal.)
250/350
色域 (Typ.)
DCI-P3 98% (CIE1976)
對比度 (Typ.)
1300:01:00
面板類型
IPS
峰值亮度 (Typ.)
450
點距
0.18159(H)mm x 0.18159(V)mm
反應時間 (GtG)
14ms (Off), 5ms (Faster)
防眩光處理
Anti-Glare
可視角度 (CR≥10)
178(R/L), 178(U/D)
特色
環境光感測器
Yes
黑色場景穩定模式
Yes
出廠色彩校正
Yes (Delta E<5, Gamma 1.8~2.6/DICOM curve)
DICOM模式
Yes (<=10%)
色溫
6500K/8500K/9300K Manual (5000K ~ 10000K)
不閃爍
Yes
HDR
HDR 10
HDR效果
Yes
硬體校色支援
Yes (PerfectLum)
螢幕操作介面(OSD)語言
17國語言
PBP
Yes (2PBP)
病理學模式
Yes
顯示模式
(SDR) Custom, Mono, Pathology, Reader, Vivid, HDR Effect, DICOM (Clinical), DICOM (Diagnostic), Calibration 1, Calibration 2, (HDR) Custom, Vivid, Standard
閱讀模式
Yes
智慧節能省電模式
Yes
增加影像解析度 (SR)Super Resolution+
Yes
亮度一致性
Yes
軟體支援
雙向控制設定 (Dual Controller)
Yes
智慧螢幕操作 (OnScreen Control/ LG Screen Manager)
Yes
Qubyx 軟體
Yes
連接性
DP 版本
1.4
DisplayPort
Yes (2ea)
HDMI
Yes (1ea)
HDMI 版本
2.0
USB Downstream Port
Yes (2ea/ver2.0)
USB Upstream Port
Yes (1ea/ver2.0)
設計
支架調整
傾角/高度/樞軸旋轉
高度調整
0~110mm
樞軸旋轉方向
雙向
壁掛
100 x 100 mm
尺寸/重量
尺寸 (含紙箱) (寬x高x深)
822 X 537 X 215 mm
尺寸 (含支架) (寬x高x深)
718.2 X 598.0 X 231.2 mm (最高)718.2 X 488.0 X 231.2 mm (最低)
尺寸 (不含支架) (寬x高x深)
718.2 X 414.3 X 45.1 mm
重量 (含支架)
7.3kg
重量 (不含支架)
5.9kg
規範
IEC (IEC 60601-1 / IEC 60601-1-2)
Yes
EN (EN 60601-1 / EN 60601-1-2)
Yes
cUL (ANSI/AAMI ES 60601-1, CSA CAN/CSA-C22.2 NO. 60601-1)
Yes
FCC (FCC part 15 Class A)
Yes
FDA
510 (k) (Class II)
CE (MDD 93/42/EEC, 2007/47/EC)
Yes
ISO13485
Yes
GMP
Yes
KGMP
Yes
RoHS
Yes
REACH
Yes
WEEE
Yes
MFDS
Yes